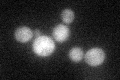
YIL128W
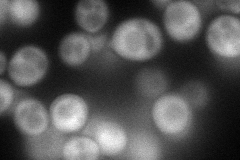
YIL128W
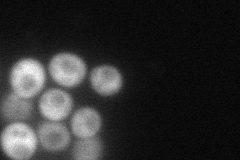
YIL128W
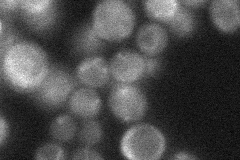
YIL128W
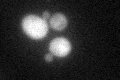
YIL128W
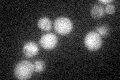
YIL128W

View description
DNA repair and TFIIH regulator, required for both nucleotide excision repair (NER) and RNA polymerase II (RNAP II) transcription; involved in telomere maintenance
Localization:
Intensity:
Fold change:
Significance:
-
C’ GFP library in SD
cytosol35.42 -
N' NOP1pr-GFP in SD
cytosol87.144 -
N' TEF2pr-mCherry in SD
cytosol80.1772 -
N' NATIVEpr-GFP in SD
cytosol30.4926 -
N' TEF2pr-VC and Cyto-VN in SD

#N/A0 -
C’ GFP library in SD+DTT
cytosol34.550.97No -
C’ GFP library in SD+H2O2

cytosol39.131.1No -
C’ GFP library in Starvation Media
cytosol27.180.76No -
C’ GFP library on the background of Pup2-DaMP

cytosol -
C’ GFP library on the background of CCT mutant

cytosol41.45041.16997No
